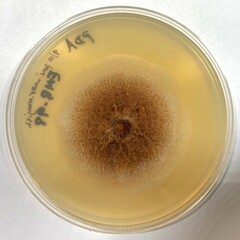
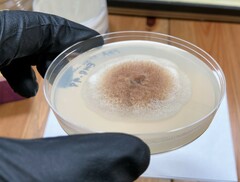
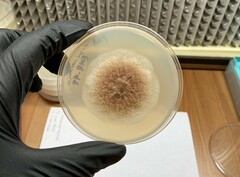
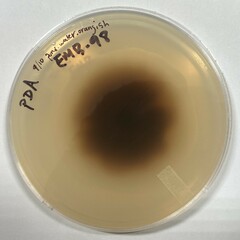

Aquanectria: taxon details and analytics
- Domain
- Kingdom
- Fungi
- Phylum
- Ascomycota
- Class
- Sordariomycetes
- Order
- Hypocreales
- Family
- Nectriaceae
- Genus
- Aquanectria
- Species
- Scientific Name
- Aquanectria
Parent Taxon
Sibling Taxa
- Acremoniopsis
- Albonectria
- Allantonectria
- Aquanectria
- Atractium
- Bisifusarium
- Calonectria
- Calostilbe
- Chaetopsina
- Ciliciopodium
- Corallomycetella
- Corallonectria
- Corinectria
- Cosmospora
- Cosmosporella
- Cyanonectria
- Cylindrium
- Cylindrocladiella
- Cylindromonium
- Dialonectria
- Fusarium
- Fusicolla
- Geejayessia
- Gliocephalotrichum
- Gliocladiopsis
- Ilyonectria
- Macroconia
- Mariannaea
- Microcera
- Murinectria
- Nalanthamala
- Nectria
- Neocosmospora
- Neonectria
- Payosphaeria
- Penicillifer
- Pseudocosmospora
- Pseudonectria
- Rectifusarium
- Sarcopodium
- Stylonectria
- Thelonectria
- Thyronectria
- Xenoacremonium
- Xenonectriella